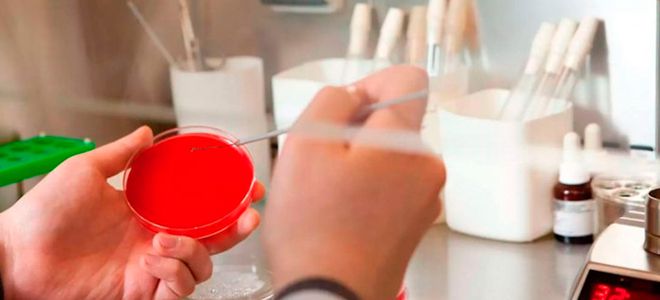
анализ на впч как берут у женщин анализ на впч как берут у женщин

Вирус папилломы человека (ВПЧ) — одна из самых распространенных инфекций, передающихся половым путем, с серьезным влиянием на здоровье женщин. ВПЧ может вызывать предраковые состояния и рак шейки матки, что делает его важной темой в гинекологии. В статье рассмотрим, что такое ВПЧ, методы диагностики, лечения и профилактики. Эти знания помогут женщинам осознать риски, связанные с ВПЧ, и принимать обоснованные решения о своем здоровье.
Что это такое ВПЧ?
Инфекционное заболевание, известное как вирус папилломы человека (ВПЧ), встречается у людей всех возрастов. Когда речь идет о ВПЧ у женщин, важно отметить, что это общее название для множества вирусов, способных вызвать различные заболевания в организме. Специалисты уже долгое время занимаются разработкой вакцины, которая могла бы эффективно бороться с этим вирусом, однако пока достичь этой цели не удалось. Тем не менее, ученые разработали методы диагностики, позволяющие выявить вирус в организме, а также создали вакцину для защиты от заражения.
ВПЧ, или вирус папилломы человека, представляет собой группу вирусов, которые могут вызывать различные заболевания, включая рак шейки матки. Эксперты подчеркивают важность регулярного скрининга, который включает Пап-тест и тест на ВПЧ. Эти методы позволяют выявить предраковые изменения на ранних стадиях. Лечение может варьироваться от наблюдения до хирургического вмешательства, в зависимости от степени поражения. Профилактика включает вакцинацию, которая эффективна против наиболее опасных штаммов вируса. Кроме того, соблюдение правил безопасного секса и укрепление иммунной системы также играют важную роль в снижении риска заражения. Важно, чтобы женщины были информированы о ВПЧ и регулярно проходили обследования для своевременного выявления и лечения возможных заболеваний.
https://youtube.com/watch?v=2Tiz_apmMPQ
Типы ВПЧ у женщин
Существует множество разновидностей вируса, их насчитывается более 70. Чтобы разобраться в том, что такое ВПЧ у женщин, полезно рассмотреть следующую классификацию:
- ВПЧ, при котором возникают различные виды бородавок.
- ВПЧ 16 типа у женщин поражает половые органы и дыхательные пути. К этому типу также относятся другие разновидности: 6, 11, 13, 18, 31, 33 и 35.
- Вирусы, проявляющиеся в виде кожных высыпаний и ассоциированные с предраковыми состояниями.
| Аспект | Описание | Рекомендации |
|---|---|---|
| Что такое ВПЧ? | Вирус папилломы человека (ВПЧ) – это группа вирусов, которые могут вызывать различные заболевания, от бородавок до рака. Существует более 200 типов ВПЧ, некоторые из которых считаются высокоонкогенными (способными вызывать рак). | Важно знать, что не все типы ВПЧ опасны. |
| Как передается? | ВПЧ передается преимущественно половым путем, включая вагинальный, анальный и оральный секс. Контакт кожи к коже в области гениталий также может быть путем передачи. | Использование презервативов снижает риск, но не исключает его полностью, так как вирус может находиться на участках кожи, не покрытых презервативом. |
| Симптомы у женщин | Часто ВПЧ протекает бессимптомно. Видимые проявления могут включать: – Генитальные бородавки (кондиломы) – Изменения на шейке матки, которые выявляются при гинекологическом осмотре и цитологическом исследовании. |
Регулярные гинекологические осмотры и скрининг очень важны для раннего выявления. |
| Диагностика | – Цитологическое исследование (ПАП-тест/мазок по Папаниколау): Выявляет атипичные клетки на шейке матки. – ВПЧ-тест: Определяет наличие вируса и его тип (высокоонкогенный или низкоонкогенный). – Кольпоскопия: Осмотр шейки матки под увеличением для выявления патологических изменений. – Биопсия: Взятие образца ткани для гистологического исследования при подозрении на предраковые или раковые изменения. |
Регулярный скрининг рекомендован всем женщинам, начиная с определенного возраста (обычно с 21 года или 25 лет, в зависимости от рекомендаций страны). |
| Лечение | ВПЧ не лечится, но лечатся его проявления. – Генитальные бородавки: Удаление (лазер, криодеструкция, электрокоагуляция, химические методы, хирургическое иссечение). – Предраковые изменения шейки матки (дисплазия): Наблюдение, конизация, петлевая электроэксцизия (LEEP), лазерная вапоризация. – Рак шейки матки: Хирургическое лечение, лучевая терапия, химиотерапия. |
Выбор метода лечения зависит от типа и степени поражения, а также от индивидуальных особенностей пациентки. |
| Профилактика | – Вакцинация: Существуют вакцины против ВПЧ, которые защищают от наиболее опасных типов вируса, вызывающих рак шейки матки и другие ВПЧ-ассоциированные заболевания. Рекомендуется девочкам и молодым женщинам до начала половой жизни. – Безопасный секс: Использование презервативов снижает риск, но не исключает его полностью. – Регулярные гинекологические осмотры и скрининг: Раннее выявление и лечение предраковых состояний. – Ограничение числа половых партнеров. |
Вакцинация является наиболее эффективным методом профилактики ВПЧ-ассоциированных заболеваний. |
Интересные факты
Вот несколько интересных фактов о вирусе папилломы человека (ВПЧ) у женщин:
-
Разнообразие типов ВПЧ: Существует более 200 типов вируса папилломы человека, из которых около 40 могут передаваться половым путем. Некоторые из них, такие как типы 16 и 18, являются высокоонкогенными и могут привести к развитию рака шейки матки, в то время как другие типы вызывают доброкачественные образования, такие как бородавки.
-
Скрининг и вакцинация: Регулярные скрининги, такие как Пап-тест и тест на ВПЧ, помогают выявить предраковые изменения в шейке матки на ранних стадиях. Вакцинация против ВПЧ, которая рекомендуется для девочек и мальчиков в возрасте 11-12 лет, может значительно снизить риск развития рака шейки матки и других связанных заболеваний.
-
Иммунная система и самоизлечение: В большинстве случаев иммунная система женщины способна самостоятельно справиться с инфекцией ВПЧ в течение 1-2 лет. Однако в некоторых случаях вирус может оставаться в организме в неактивной форме и активироваться позже, что подчеркивает важность регулярного мониторинга и профилактических мер.
https://youtube.com/watch?v=XqQRwpxvEgc
Чем опасен ВПЧ?
На первый взгляд, маленькая и безобидная папиллома может скрывать серьезную угрозу. Это новообразование, возникающее из-за активности вируса, представляет собой доброкачественную опухоль. Однако вирус папилломы человека у женщин опасен тем, что некоторые его штаммы способны в любой момент трансформироваться в злокачественное образование. Физические травмы и воспалительные процессы могут стать триггерами для такого перерождения.
Папилломавирус у женщин – причины возникновения
На начальных этапах своего развития заболевание может проявляться в скрытой форме, что может длиться от 2 до 3 месяцев. Папилломавирус человека может быть активирован рядом факторов:
- ослабленным иммунитетом и частыми стрессами;
- наличием вредных привычек;
- ранним началом половой жизни и незащищенными случайными связями;
- наличием половых инфекций;
- беременностью;
- длительными заболеваниями, такими как грипп и расстройства желудочно-кишечного тракта.
https://youtube.com/watch?v=497vOdR-oK8
Как передается вирус папилломы человека?
Инфекция может передаваться при контакте с инфицированными людьми или животными, независимо от наличия или отсутствия у них клинических проявлений. Говоря о том, как происходит заражение папилломавирусом, важно отметить, что он часто проникает в организм через мелкие повреждения кожи или при вдыхании.
- По статистическим данным, риск заражения значительно возрастает в местах с высокой концентрацией людей, особенно в условиях повышенной влажности, таких как бассейны и сауны.
- Объясняя, что такое ВПЧ у женщин, следует подчеркнуть, что инфекция может передаваться при половых контактах с носителем, включая как традиционные, так и оральные формы. Также существует вероятность передачи вируса во время родов.
Вирус папилломы человека у женщин – симптомы
Многочисленные исследования показали, что у значительного числа людей вирус папилломы человека (ВПЧ) не вызывает никаких симптомов, и его можно выявить только с помощью специального теста. Симптомы ВПЧ наблюдаются лишь у небольшой части людей и, как правило, на короткий срок, проявляясь в виде кондилом. Эти образования имеют небольшой размер, могут быть розового или телесного цвета и обладают слегка бугристой поверхностью. Чаще всего они возникают в области половых органов. Примечательно, что примерно в 20% случаев такие образования исчезают самостоятельно в течение нескольких месяцев.
ВПЧ – диагностика
Бородавки и кондиломы можно легко выявить при визуальном осмотре. Для подтверждения наличия вируса папилломы человека (ВПЧ) и определения его типа применяются методы ПЦР и «гибридного захвата». Если у женщин обнаруживается ВПЧ, в гинекологии, при подозрении на возможные осложнения, проводятся дополнительные исследования:
- Кольпоскопия позволяет детально изучить шейку матки для выявления патологических изменений. В процессе этого исследования выполняются различные диагностические пробы.
- Биопсия пораженных участков тканей помогает установить наличие злокачественных образований.
- Говоря о том, что такое ВПЧ у женщин и как его диагностировать, стоит также упомянуть о цитологическом исследовании, которое проводится всем женщинам, даже если визуально шейка матки не имеет изменений.
Анализ на ВПЧ – как берут у женщин?
Врач осуществляет ряд диагностических процедур, среди которых обязательно проводится гинекологический осмотр для выявления бородавок и кондилом. Исследование на вирус папилломы человека включает в себя цитологический мазок, в ходе которого анализируются соскобы с шейки матки, полученные из слизистой и цервикального канала. Этот метод позволяет обнаружить рак на ранних стадиях. Для диагностики наличия папилломавируса у женщин специалисты применяют кольпоскопию, биопсию и полимеразную цепную реакцию, которая позволяет выявить ДНК вируса.
Вирус папилломы человека у женщин – лечение
Для достижения оптимальных результатов требуется всестороннее обследование. Врач подбирает необходимые препараты и осуществляет удаление существующих папиллом. Говоря о том, как лечить папилломавирус, стоит отметить, что для этого применяются жидкий азот и лазер. Эффективными методами также являются прижигания с использованием специализированных медицинских средств. В случаях значительных образований может потребоваться хирургическое вмешательство.
Выбор метода удаления основывается на результатах осмотра, а также на количестве наростов, их расположении и плотности. Если выявлен вирус папилломы человека, лечение наростов может проводиться оперативно под анестезией, особенно если на лобковой области имеется множество образований. В случае небольших поражений применяются методы прижигания и лазерного воздействия. Иногда после удаления папилломы они могут появляться вновь, и в таких случаях также используется прижигание.
Лечение ВПЧ у женщин – препараты
Полностью избавиться от данного заболевания у женщин практически невозможно. Кроме того, стоит отметить, что лечение требует значительных финансовых затрат. Крайне важно завершить весь курс, назначенный специалистом, иначе добиться положительных результатов не удастся. Если вас интересует, как осуществляется лечение ВПЧ у женщин, то следует выделить основные категории лекарственных средств:
-
Противовирусные препараты предназначены для разрушения структуры ВПЧ и предотвращения его распространения. Существуют различные формы этих средств, и выбор зависит от характера заболевания и локализации кондилом. В аптеках можно найти противовирусные препараты в виде мазей, кремов, инъекционных растворов, таблеток и других форм (например, Гропринозин, Ацикловир). Уколы и таблетки считаются наиболее эффективными.
-
Лечение ВПЧ у женщин часто включает средства для местного применения. После удаления образований важно обрабатывать пораженные участки специальными гелями (например, Эпиген-гель).
-
При выявлении папилломавируса лечение может включать свечи, которые предотвращают распространение воспалительных процессов в области влагалища. Они также способствуют укреплению иммунной системы и предотвращают прогрессирование заболевания (например, Панавир, Галавит). Рекомендуемая суточная доза составляет 1-2 свечи, точное количество определяет врач с учетом дозировки. Курс применения обычно составляет 10 дней, но в некоторых случаях может быть продлен до 14 дней.
-
Необходимым средством при лечении папилломавируса являются иммуномодуляторы. Эти препараты необходимы для укрепления иммунной системы и назначаются исключительно врачами (например, Кордицепс, Деринат).
Прививка от вируса папилломы человека
Фармацевтическая отрасль предлагает два вида вакцин, которые помогают защититься от вируса папилломы человека (ВПЧ) типов 16 и 18 — это Церварикс и Гардасил. Исследования показали, что данные генотипы ВПЧ у женщин часто становятся причиной развития онкологических заболеваний. Вакцины также обеспечивают перекрестную защиту от других типов ВПЧ. Рекомендуется проводить вакцинацию девушкам до начала половой жизни. По рекомендациям Всемирной организации здравоохранения, оптимальный возраст для вакцинации составляет 9-13 лет. Для защиты от рака шейки матки вакцину могут получать и девушки, которые уже ведут половую жизнь. Вакцинация включает три инъекции, которые вводятся с интервалом в 1, 2 и 6 месяцев.
Профилактика ВПЧ у женщин
Профилактика вируса папилломы человека (ВПЧ) у женщин играет ключевую роль в снижении риска развития связанных с ним заболеваний, включая рак шейки матки. Существует несколько эффективных методов, которые могут помочь в предотвращении заражения ВПЧ и его последствий.
Вакцинация
Одним из самых эффективных способов профилактики ВПЧ является вакцинация. Существуют вакцины, которые защищают от наиболее распространенных и высокоонкогенных типов вируса, таких как ВПЧ 16 и 18. Вакцинация рекомендуется для девочек и женщин в возрасте от 9 до 26 лет, но может быть полезна и для более старших женщин, особенно если они не были ранее вакцинированы. Вакцина вводится в виде серии инъекций, и для достижения максимальной защиты важно пройти полный курс вакцинации.
Регулярные медицинские осмотры
Регулярные гинекологические осмотры и скрининг на наличие предраковых изменений шейки матки, такие как Пап-тест (цитология) и тест на ВПЧ, являются важными мерами профилактики. Эти процедуры позволяют выявить изменения на ранних стадиях, что значительно увеличивает шансы на успешное лечение. Рекомендуется проходить такие обследования не реже одного раза в три года, начиная с 21 года.
Безопасные сексуальные практики
Использование барьерных методов контрацепции, таких как презервативы, может снизить риск передачи ВПЧ. Хотя презервативы не обеспечивают 100% защиту от вируса, они значительно уменьшают вероятность заражения. Также важно ограничить количество половых партнеров и избегать случайных связей, что также снижает риск заражения.
Здоровый образ жизни
Поддержание здорового образа жизни может помочь организму справляться с инфекцией ВПЧ. Это включает в себя сбалансированное питание, регулярные физические нагрузки, отказ от курения и умеренное потребление алкоголя. Употребление достаточного количества витаминов и минералов, особенно витамина С и фолиевой кислоты, может поддерживать иммунную систему и способствовать борьбе с вирусом.
Информированность и образование
Образование и информированность о ВПЧ, его последствиях и методах профилактики играют важную роль в борьбе с вирусом. Женщинам следует быть осведомленными о рисках, связанных с ВПЧ, и о том, как защитить себя и своих партнеров. Проведение образовательных программ и кампаний по повышению осведомленности может помочь в снижении уровня заболеваемости и смертности от рака шейки матки.
Таким образом, профилактика ВПЧ у женщин включает в себя вакцинацию, регулярные медицинские осмотры, безопасные сексуальные практики, здоровый образ жизни и повышение информированности. Применение этих методов может значительно снизить риск заражения и развития серьезных заболеваний, связанных с ВПЧ.
Вопрос-ответ
Как вывести вирус ВПЧ из организма?
Резюме. Специфического лечения пациента, зараженного вирусом папилломы человека, не существует. Единственный действенный метод предотвратить заражение — вакцинация.
Какой витамин убивает ВПЧ?
Результаты фундаментальных и клинических исследований показывают необходимость компенсации дефицита витамина D для успешной терапии вирусных гепатитов, респираторных инфекций, ВПЧ.
Что болит при ВПЧ у женщин?
Чаще всего страдает шейка матки, но по статистике многие раковые поражения рта, миндалин, глотки или ануса также оказались вызваны этим вирусом. Однако ВПЧ не всегда вызывает заболевание.
Советы
СОВЕТ №1
Регулярно проходите гинекологические обследования, включая Пап-тест и тест на ВПЧ. Это поможет выявить вирус на ранних стадиях и предотвратить развитие серьезных заболеваний, таких как рак шейки матки.
СОВЕТ №2
Обсудите с врачом возможность вакцинации против ВПЧ. Вакцинация может значительно снизить риск заражения высокоонкогенными штаммами вируса и защитить от развития связанных с ним заболеваний.
СОВЕТ №3
Соблюдайте правила безопасного секса, включая использование презервативов. Это поможет снизить риск передачи ВПЧ и других инфекций, передающихся половым путем.
СОВЕТ №4
Поддерживайте здоровый образ жизни: правильно питайтесь, занимайтесь физической активностью и избегайте курения. Это укрепит вашу иммунную систему и поможет организму бороться с вирусами, включая ВПЧ.